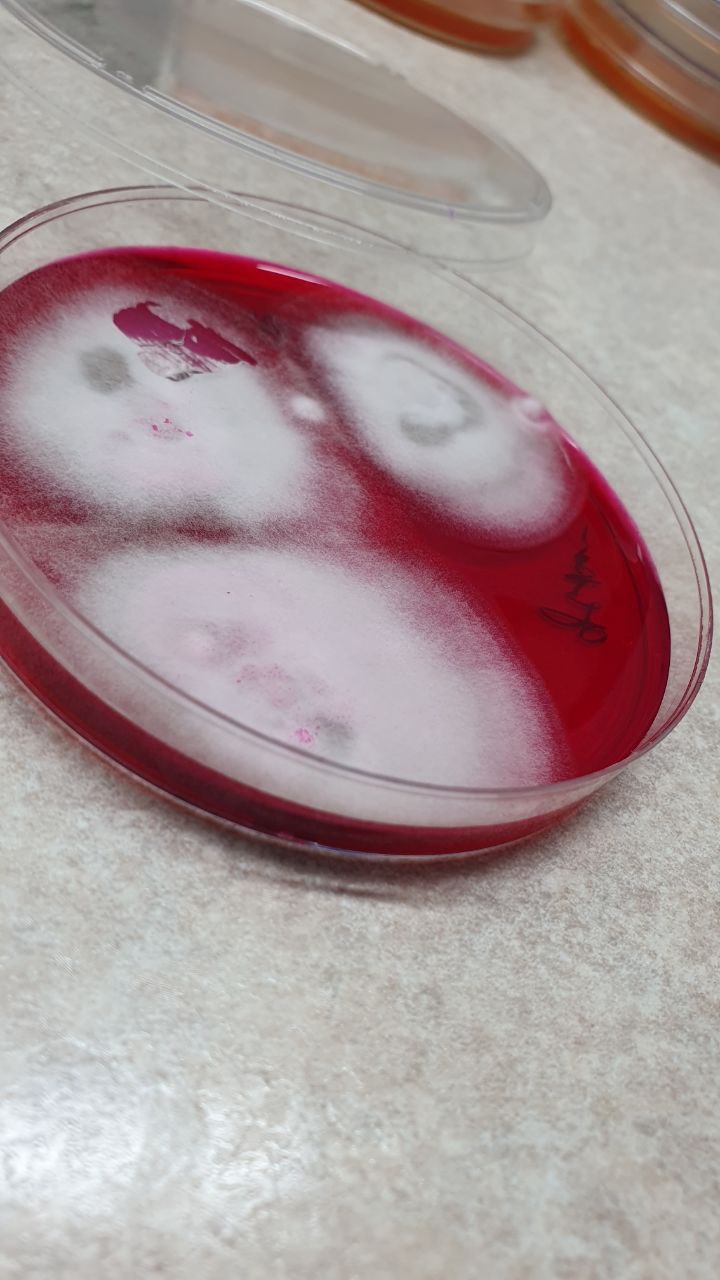

Подологический педикюр
Подологический и эстетический маникюр

Проблема вросшего ногтя

Исправление деформированных ногтей

Коррекционные системы

Восстановление травмированных ногтей

Протезирование ногтей

Грибок, утолщение ногтей
Удаление мозолей
Обработка трещин
Обработка натоптышей

Отслоение ногтевой пластины
Анализ на грибок кожи и ногтей
Диагностика стоп
Ортопедические стельки
Выведение бородавок
Изготовление силиконовых ортозов
Анализ на грибок кожи и ногтей
В подологическом центре PodoExperts опытные специалисты соберут материал с Ваших ногтей и кожи, чтобы выполнить анализ на грибок
Забор материала + передача в лабораторию. В анализ входит посев на питательные среды с кожи и ногтей. Определение чувствительности грибов к антимикотикам для перорального и наружного применения.
Выбрать другую услугу- Анализ на грибковую флору /кожа, ногти/ 1100 грн (30 мин)
Результаты наших пациентов